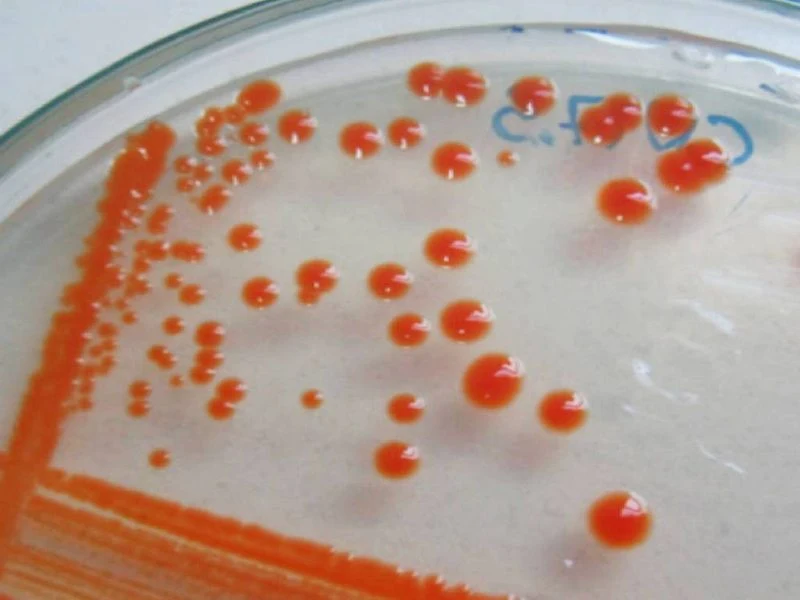

En las remotas tierras de la Isla Rey Jorge, en la Antártica, los investigadores de la Universidad de Los Lagos pudieron aislar la bacteria conocida como flavobacterium, un tipo de organismo que vive en muchos ambientes del planeta. "Pero al crecer en un clima tan frío como el que lo encontramos, tiene la posibilidad de desarrollarse muy rápido si se la cultiva en temperaturas más altas", explica Álex González, doctor en Biotecnología y académico de la universidad. Lo han comprobado en los laboratorios de la institución, en Osorno, donde han mantenido el microorganismo en refrigeración y al ambiente.
Ya que se reproduce rápido y tiene un intenso color naranja, los investigadores pretenden darle un uso comercial. "Pensamos que con él podemos desarrollar un pigmento orgánico que permita darle el color a los salmones de la industria salmonera", comenta González.
-Un momento, profesor: ¿los salmones necesitan ayuda para ser naranjos?
-Sí, deben consumir algún tipo de suplemento para adquirir su color. De otra forma su carne sería blanca.
Sandra Bravo, directora del Instituto de Acuicultura de la Universidad Austral, explica que en la naturaleza los salmones adquieren su tono anaranjado debido a su comida: de seres como crustáceos consiguen una sustancia llamada astaxantina, que le otorga su tonalidad fascinante.
Pero los que crecen en cultivos industriales no tienen ese alimento a su alcance, por lo que necesitan algo que les otorgue su color.
"Actualmente -explica el profesor González- se les dan compuestos de tipo químico, pero debido a que los consumidores han adquirido una mayor conciencia ambiental, podrían preferir alternativas naturales. Actualmente hay un producto en base a organismos y elaborado por laboratorios europeos, pero resulta más caro".
-¿Y por qué estas flavobacterium podrían funcionar?
-Estas bacterias pueden crecer mejor a temperatura ambiente y para su crecimiento óptimo debe estar entre 12 y 14 grados. La foto que te compartí (en que se ven puntos naranjas) son colonias de bacterias: cada puntito mide unos 8 mm y allí viven cientos de millones de bacterias. Así se convertiría en una alternativa más barata y rápida de producir. Esperamos confirmarlos en nuestra facultad.
González explica que un producto en base a la bacteria sería integrado a la comida de los salmones y eso les daría el color deseado. Igualmente, añade, podría ser administrado a gallinas: así aportaría un tono más vivo a las yemas de los huevos. O incorporado a los pollos, tendrían una carne más colorida.
La profesora Bravo dice que en Chile todas las plantas de producción de salmones usan astaxantica sintética. "Hasta ahora, la astaxantina de origen natural no ha logrado competir por precio y por estabilidad del pigmento", indica. Y agrega que hay un mercado para productos más orgánicos, pero cumplir todas las normativas y ganarse ese rótulo encarece el costo.
"La industria salmonera en Chile -detalla Bravo- produce un millón de toneladas al año y se ubica en segundo lugar en el mundo tras Noruega, que alcanza 1,3 millones de toneladas. Son volúmenes gigantes".